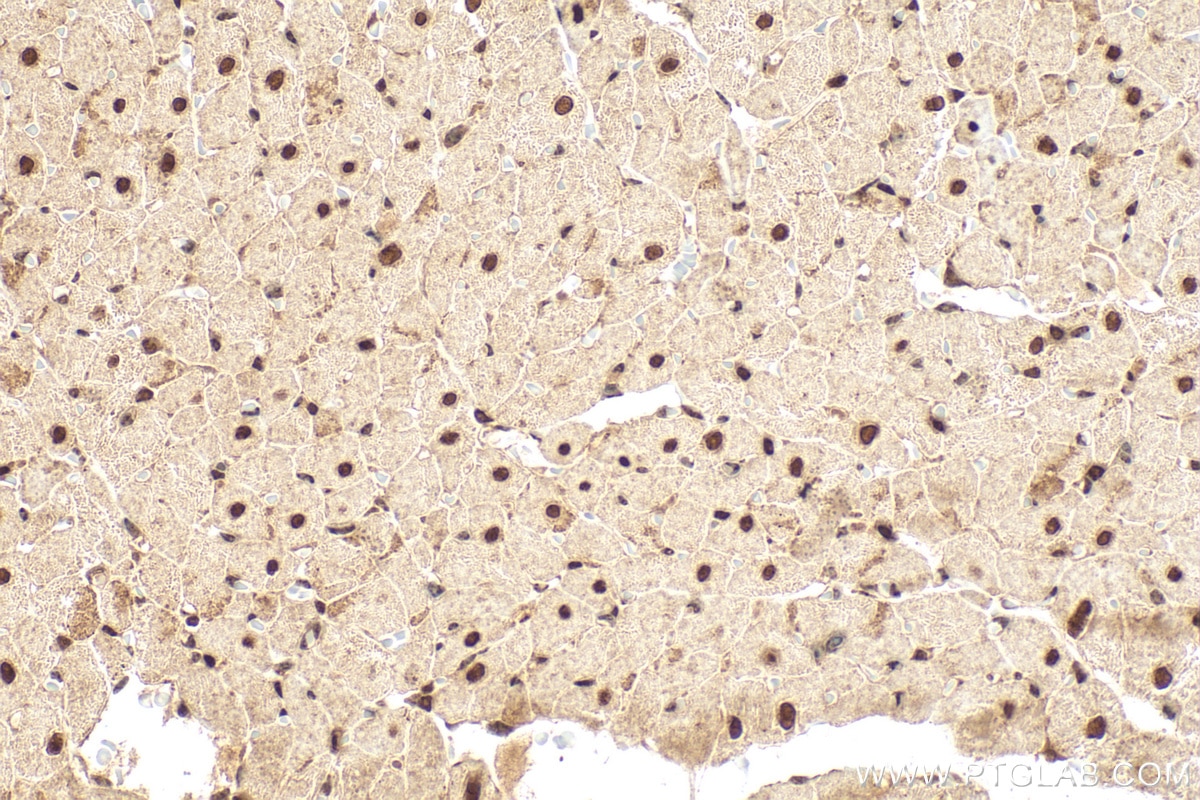
Immunohistochemical analysis of paraffin-embedded rat heart tissue slide using 13120-1-AP (TEAD3 antibody) at dilution of 1:400 (under 40x lens). Heat mediated antigen retrieval with Tris-EDTA buffer (pH 9.0). Immunohistochemistry (IHC) staining of rat heart tissue using TEAD3 Polyclonal antibody (13120-1-AP)

Tested Applications
| Positive WB detected in | HCT 116 cells, HepG2 cells, MCF-7 cells, L02 cells, MDA-MB-231 cells |
| Positive IHC detected in | rat heart tissue, mouse intestine Note: suggested antigen retrieval with TE buffer pH 9.0; (*) Alternatively, antigen retrieval may be performed with citrate buffer pH 6.0 |
| Positive IF/ICC detected in | MCF-7 cells |
Recommended dilution
| Application | Dilution |
|---|---|
| Western Blot (WB) | WB : 1:500-1:2000 |
| Immunohistochemistry (IHC) | IHC : 1:200-1:800 |
| Immunofluorescence (IF)/ICC | IF/ICC : 1:50-1:500 |
| It is recommended that this reagent should be titrated in each testing system to obtain optimal results. | |
| Sample-dependent, Check data in validation data gallery. | |
Published Applications
| WB | See 7 publications below |
| IHC | See 1 publications below |
Product Information
13120-1-AP targets TEAD3 in WB, IHC, IF/ICC, ELISA applications and shows reactivity with human, mouse samples.
| Tested Reactivity | human, mouse |
| Cited Reactivity | human, mouse |
| Host / Isotype | Rabbit / IgG |
| Class | Polyclonal |
| Type | Antibody |
| Immunogen |
CatNo: Ag3875 Product name: Recombinant human TEAD3 protein Source: e coli.-derived, PGEX-4T Tag: GST Domain: 1-324 aa of BC027877 Sequence: MNLDQVSKDKALQSMASMSSAQIVSASVLQNKFSPPSPLPQAVFSTSSRFWSSPPLLGQQPGPSQDIKPFAQPAYPIQPPLPPTLSSYEPLAPLPSAAASVPVWQDRTIASSRLRLLEYSAFMEVQRDPDTYSKHLFVHIGQTNPAFSDPPLEAVDVRQIYDKFPEKKGGLKELYEKGPPNAFFLVKFWADLNSTIQEGPGAFYGVSSQYSSADSMTISVSTKVCSFGKQVVEKVETEYARLENGRFVYRIHRSPMCEYMINFIHKLKHLPEKYMMNSVLENFTILQVVTSRDSQETLLVIAFVFEVSTSEHGAQHHVYKLVKD Predict reactive species |
| Full Name | TEA domain family member 3 |
| Calculated Molecular Weight | 435 aa, 49 kDa |
| Observed Molecular Weight | 50 kDa |
| GenBank Accession Number | BC027877 |
| Gene Symbol | TEAD3 |
| Gene ID (NCBI) | 7005 |
| RRID | AB_2203068 |
| Conjugate | Unconjugated |
| Form | Liquid |
| Purification Method | Antigen affinity purification |
| UNIPROT ID | Q99594 |
| Storage Buffer | PBS with 0.02% sodium azide and 50% glycerol, pH 7.3. |
| Storage Conditions | Store at -20°C. Stable for one year after shipment. Aliquoting is unnecessary for -20oC storage. 20ul sizes contain 0.1% BSA. |
Background Information
TEAD3, others named ranscriptional enhancer factor 5(TEF5), a member of family of transcription factors that plays a key role in the Hippo signaling pathway, suggesting involve in organ and tumor suppression by restricting proliferation and promoting. TEAD3 contains the TEA/ATTS DNA-binding domain. Human TEAD3 has a strong mRNA expression in placenta and choriocarcinoma cells(JEG-3), but low in Hela, HepG2 and MCF-7. This is a rabbit polyclonal anti-TEAD3 antibody raised against part of C-terminal chain of human TEAD3.
Protocols
| Product Specific Protocols | |
|---|---|
| WB protocol for TEAD3 antibody 13120-1-AP | Download protocol |
| IF protocol for TEAD3 antibody 13120-1-AP | Download protocol |
| IHC protocol for TEAD3 antibody 13120-1-AP | Download protocol |
| Standard Protocols | |
|---|---|
| Click here to view our Standard Protocols |
Publications
| Species | Application | Title |
|---|---|---|
Res Sq Long noncoding RNA Malat1 inhibits Tead3-Nfatc1-mediated osteoclastogenesis to suppress osteoporosis and bone metastasis | ||
J Med Chem Selective Degradation of TEADs by a PROTAC Molecule Exhibited Robust Anticancer Efficacy In Vitro and In Vivo | ||
Cell Stem Cell Molecular signature of primate astrocytes reveals pathways and regulatory changes contributing to human brain evolution | ||
Cell Death Dis Mechanical signal modulates prostate cancer immune escape by USP8-mediated ubiquitination-dependent degradation of PD-L1 and MHC-1 | ||